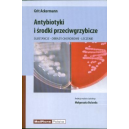
Antybiotyki i środki przeciwgrzybicze Substancje, obrazy chorobowe, leczenie

Właściwe leczenie antybiotykami wymaga fachowej wiedzy i odpowiedniego
doświadczenia, tak aby zastosowana terapia była skuteczna, niedroga i dobrze
tolerowana przez pacjenta.
Niniejsza książka obejmuje wiedzę z zakresu antybiotyków, leków
przeciwgrzybiczych, jak i przeciwgruźliczych.
W książce można znaleźć dane na temat: farmakokinetyki i dawkowania
leków, również u pacjentów z chorobami nerek, schematów terapii zastępczej w
różnych chorobach infekcyjnych, zakresu działania leków i profile oporności
bakterii na antybiotyki.
Książka jest doskonałą pomocą i uzupełnieniem aktualnej wiedzy zarówno dla
praktykujących lekarzy, jak również studentów medycyny i
farmaceutów.
Spis treści:I. PODSTAWY
- Definicje
- Farmakokinetyka
- Farmakodynamika
- Podstawy odpowiedzi immunologicznej
- Wskazówki do racjonalnego stosowania antybiotyków
II. ANTYBIOTYKI WRAZ Z LEKAMI PRZECIWGRUŹLICZYMI I PRZECIWGRZYBICZYMI
- Penicyliny
- Inhibitory Beta-laktamaz
- Cefalosporyny
- Karbapenemy i monobaktamy
- Aminoglikozydy
- Makrolidy, azalidy i ketolidy
- ....
III. LECZENIE ZAKAŻEŃ WYWOŁANYCH PRZEZ WYBRANE DROBNOUSTROJE
IV. LECZENIE SEPSY I CHORÓB SWOISTYCH
V. LECZENIE PRZECIWDROBNOUSTROJOWE WYBRANYCH GRUP PACJENTÓW
Aneks. Spis gotowych leków zarejestrowanych
Literatura
Skorowidz